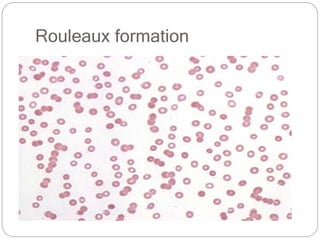
Rouleaux formation

This document provides an overview of crossmatching procedures in blood banking. It discusses the types of crossmatches (major vs minor), methods (manual vs electronic), and steps involved. It also covers incompatible crossmatches and potential causes such as incorrect blood grouping, presence of alloantibodies, or autoantibodies. Solutions for incompatible crossmatches include verifying the identity of samples, performing additional tests like antibody identification, and using antigen-negative blood units. The document also discusses concepts like rouleaux formation, different types of Coombs tests (direct vs indirect), and antibody titration.